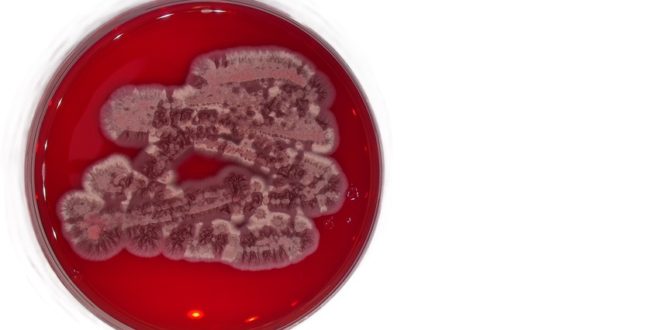

Účinnost některých gunacinů byla dokonce vyšší než u amfotericinu B.
Nečekaný objev hlásí vědci z Mikrobiologického ústavu AV ČR. V druhu mikroskopické houby, která běžně žije na rostlinách po celém světě, identifikovali zcela nové látky s mimořádným potenciálem. Tyto sloučeniny, pojmenované gunaciny, prokázaly v laboratorních testech silné účinky proti parazitům způsobujícím nebezpečné tropické nemoci. Chemicky jsou podobné léčivým látkám z legendárního „čaje Inků“, stromu lapacho.
Houby rodu plíška, odborně Exobasidium, parazitují na rostlinách. Vědci se zaměřili na toxiny produkované jedním z dosud nepopsaných druhů, který objevili. Překvapivě našli osm neznámých přírodních látek, které svým složením připomínají slavné lapachony – sloučeniny obsažené v kůře jihoamerického stromu lapacho. Odvary z něj po staletí využívá tradiční medicína pro jeho protizánětlivé a protinádorové účinky.
Dvě z nových látek ukázaly v testech obrovský potenciál. Dokázaly ničit parazity rodů Leishmania a Trypanosoma, původce závažných onemocnění, jako je leishmanióza nebo spavá nemoc, a to už ve velmi nízkých koncentracích.
„Účinnost některých gunacinů byla dokonce vyšší než u amfotericinu B, což je jedno z léčiv, které se v současnosti pro léčbu těchto chorob používá,“ vysvětluje členka týmu Alena Zíková z Biologického centra AV ČR.
„Nalezené látky jsou nicméně poměrně toxické, takže pro přímý vývoj léčiv je třeba hledat méně toxické deriváty. Nicméně tyto látky lze využít pro ničení parazitů přímo v přírodě,“ popisuje člen týmu, buněčný biolog Jan Černý z Přírodovědecké fakulty UK.
Houby jako nový zdroj léčiv
Rod hub Exobasidium je známý spíše jako patogen rostlin, který způsobuje ekonomické ztráty například pěstitelům čaje nebo borůvek. Studovaný nový druh byl dosud přehlížen, ale běžně roste na listech řady rostlin po celém světě, včetně České republiky.
„Je pravděpodobné, že objevené látky houbě v jejím přirozeném prostředí neslouží k napadání rostlin, ale spíše jako chemická zbraň v konkurenčním boji s jinými mikroorganismy. To potvrzují i další zjištěné vlastnosti gunacinů. Některé z nich totiž vykazovaly také účinky proti bakteriím a kvasinkám,“ popisuje vedoucí týmu Miroslav Kolařík z Mikrobiologického ústavu AV ČR (MBÚ AV ČR). „Příroda je zkrátka plná překvapení. Ukazuje se, že i organismy, které běžně vnímáme jako škůdce, mohou skrývat chemický arzenál s obrovským farmakologickým potenciálem,“ říká Miroslav Kolařík.
Jak na popis nových biologických látek
Houby sice produkují řadu neznámých chemických látek, ale jejich popis není snadný a vyžaduje odborná měření.
„Často čelíme problémům s nestabilitou a malou produkcí nové látky. K přesnému určení struktury je třeba řada expertíz, a tedy široký tým. Námi studovaná houba je výjimečná nebývale velkou kvantitou produkce,“ popisuje chemička Eva Stodůlková z MBÚ AV ČR.
Práce mohla vzniknout díky velmi komplexnímu týmu, který zahrnuje mikrobiology, chemiky, parazitology a buněčné biology z MBÚ AV ČR, Biologického centra AV ČR, Přírodovědecké fakulty UK, Helmholtzova ústavu infekčních nemocí v Německu a Univerzity v Egertonu v Keni. Vědci z MBÚ AV ČR se dále zabývají studiem nových hub, u kterých lze předpokládat výskyt nových chemických látek využitelných v biotechnologii.
Studie byla publikována v prestižním mezinárodním časopise Americké chemické společnosti ACS Omega.
Gunacins: Novel benzo[g]chromene derivatives from the fungus Exobasidium sp. and their potent anti-Leishmania and Trypanosoma activities.
https://pubs.acs.org/doi/full/10.1021/acsomega.5c01325
 Sciencemag.cz
Sciencemag.cz